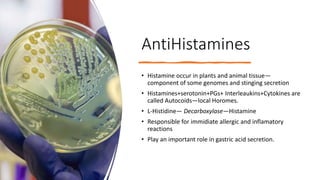
AntiHistamines
• Histamine occur in plants and animal tissue—
component of some genomes and stinging secretion
• Histamines+serotonin+PGs+ Interleaukins+Cytokines are
called Autocoids—local Horomes.
• L-Histidine— Decarboxylase—Histamine
• Responsible for immidiate allergic and inflamatory
reactions
• Play an important role in gastric acid secretion.

Decongestants and antihistamines are used to relieve nasal congestion associated with allergies and sinusitis. Oral decongestants like pseudoephedrine work by constricting blood vessels through alpha-adrenergic stimulation, while topical decongestants like oxymetazoline constrict vessels when applied nasally. First generation antihistamines block histamine H1 receptors, reducing allergic responses and symptoms, while second generation antihistamines have fewer side effects like sedation. Expectorants increase bronchial secretions to help clear mucus from the lungs, and antitussives suppress cough through central or peripheral mechanisms.